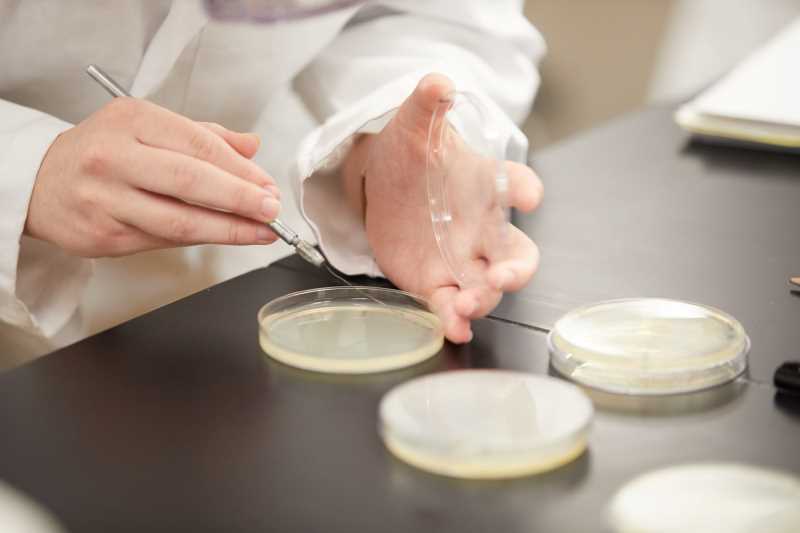

Academic programs
Explore our 130+ degree programs from undergraduate to doctoral levels in arts, social science and humanities; science and health; business; and education.
Start exploring
Refine results
Filter
Sort
Accountancy
Archaeology & Anthropology
Art
Biology
Business Administration
Chemistry & Biochemistry
Communication Studies
Computer Science & Computer Engineering
Economics
Educational Studies
English
Exercise & Sport Science
Finance
Geography & Environmental Science
Global Cultures & Languages
Health Professions
History
Information Systems
International & Global Studies
International Business
Library
Management
Marketing
Mathematics & Statistics
Microbiology
Military Science (ROTC)
Music
Philosophy
Physics
Political Science & Public Administration
Professional Studies in Education
Psychology
Public Health & Community Health Education
Race, Gender & Sexuality Studies
Recreation Management & Recreational Therapy
Sociology & Criminology
Student Affairs Administration
Sustainability & Environmental Studies
Theatre & Dance
Pre-professional
Students may choose a pre-professional track to help guide them in common requirements for graduate professional programs. Pre-professional programs are optional and are not a major or a university requirement.
Earn your degree at UW-La Crosse.
You have what it takes.
We'll take you there.
Whether you are exploring potential majors and minors, planning your career pathway,
or looking for the right preparation for graduate or professional school, UW-La Crosse has the right program for you.
19:1
Student to faculty ratio
Individualized attention
Award
No. 2 in Wisconsin
Wisconsin's top-ranked public university according to Niche's 2025 Best Colleges list.
91%
Classes with fewer than 50 students